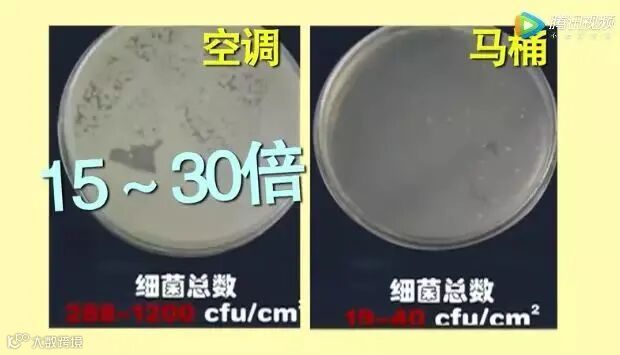

最近,全国各地都开启了“蒸桑拿”模式,出门随便走两步,汗就像瀑布。
这个时候一定要感谢两个男人,一个叫后羿,因为他射下来九个太阳;一个叫威利斯·开利,因为他发明了空调。
夏天如果没有空调,就像鱼没有水,一个会干死,一个会热死。
这比喻虽然夸张了点,但高温似火的夏天没有空调,真的不行啊啊啊啊啊!

然而,空调虽造福了人类,但不得不说它也有缺点,除了费电外,用不对还可能要人命。

吹空调前漏做一件事
37岁男子住进ICU,治疗一周还未脱险
前段时间,湖北宜昌的李先生下班回家后,因为出了一身汗,就打开了半年没用过的空调,吹了一会儿,身体不热了,但是开始咳嗽、流鼻涕。
一开始,李先生也没有在意,以为只是普通的感冒,洗个热水澡就去睡觉了。
到了深夜,李先生开始出现发热的症状,家人一看情况不对就把他送去了医院。
送到医院的时候,李先生已经出现了明显的呼吸困难。
紧急抢救后,李先生在医院ICU治疗了一周也没有完全脱离生命危险,还需要靠ECMO(人工肺)、血透机、呼吸机维持生命运转。

医生表示,李先生是比较严重的肺部感染,通过基因测序查出来是一个军团菌的感染。

这种病极其凶险,死亡率高达30%,如果患者在早期不重视或者是治疗、用药不规范,1~7天内就可能会死亡。
如果患者本人体质不好,可能在发病当天就死亡。
幸亏李先生的家人及时发现了异样,将其送往医院抢救,否则后果将不堪设想。
问题来了,李先生是怎么感染上这么凶险的致病菌的?
医生表示,军团病是一种呼吸道传染病,主要通过空气和饮用水传播,广泛存在于空调滤芯中,因此又被称为“空调病”。

李先生这次的病情,很可能就与他家不常清洗的空调有关。
和李先生一样,不洗空调的大有人在,绝大多数只知天热要开空调,殊不知未清洗的空调犹如一个定时炸弹,时刻威胁着人体的健康。
长期不清洗的空调含大量致病菌
比马桶还脏
闲置了一冬的空调,不仅积满了灰尘,还有无数的致病菌。
开机前,如果没对空调的过滤网、散热片做清洁,我们呼吸的空气,可能是比厕所还脏的“毒气”!
央视曾报道过,一年未清洗的空调,有大量金黄色葡萄球菌、芽孢杆菌等致病菌,含菌量是家用抹布的10倍,家用马桶的15-30倍!
图片来源:CCTV《生活圈》
这些细菌随呼吸道进入人体,会引起多种疾病,如过敏、呼吸道感染、腹泻、鼻炎,严重者可发生过敏性休克和败血症。
除了这些致病菌,还有上文提到的极其凶险的军团菌。
军团菌容易藏匿于空调冷却水系统中沉积物累积所形成的微生态环境中,形成含有生物被膜的细菌群体,附着式生长。
在家用空调中,过滤网和散热片是最适宜军团菌生长的理想生存环境和潜在传播源。
一旦感染通常为重症, 50%的患者需要进入重症监护室进行治疗。
还有能引起皮肤瘙痒、哮喘的螨虫,每30克的积尘中就有42000只螨虫。
这些螨虫如果落到皮肤上,可能引起丘疹性荨麻疹,痤疮等皮肤病,若是被吸进呼吸道,就会诱发鼻炎和过敏性哮喘。

有的人一进空调房就打喷嚏、咳嗽,隔三差五皮肤上出现红疙瘩,可能就是没清洗空调,里面的细菌、螨虫作怪的结果。
所以,夏季启用空调之前,务必给空调“洗个澡”,来次深度清洁。开启后每隔一个月,再清洗一次。
如何清洗空调,预防“空调病”?
有两个方法:一是请专业师傅上门清洗,二是自己动手!
如果想省一笔花销,那就自己动手洗。
清洗时不但要清洗送风口,拆卸滤网清洗,还要清洗散热片。
自己动手第一步,拔电源!
接下来,一拆二刷三喷洗。
拆:打开外壳,取出滤网。

图源/网络
刷:用软毛刷把滤网上脏东西刷出来,再用干净的水冲洗,用抹布抹干或晾干。
喷洗:空调散热片不可拆卸,可用在超市可买到的空调清洗剂进行喷洗
充分摇匀空调清洗剂瓶罐,离散热片约5cm处,喷洗散热片。

图源/网络
喷洗后,稍等15分钟左右,将过滤网装上,将干净滤网装回去,重新开空调15~30分钟,脏水会自己从排水管排走。
空调用不对,不仅关乎健康问题,还关乎“钱”的问题。
对于没房的打工人来说,每年夏天的空调费都是一笔不小的支出。
所以,为了省钱,大家有必要学学一些省电小妙招。
掌握4个小窍门,用空调更省电
1、调整出风口——向上
让空调出风口向上,就可以让冷空利用自身的物理特性自上而下,更快地“降温”。
而如果是“上下送风”模式,则会浪费掉一部分冷气。
2、拉上浅色的窗帘
在正午的时候,阳光很晒,最好把窗帘拉上,再使用空调,房间比不拉窗帘会更凉爽。
如果你家是浅色的窗帘,那就更好了,因为浅色窗帘对光的反射率高,吸收的热量少,也就更好地把“热”挡在室外了。
3、半小时内不要频繁开关空调
很多人觉得吹一会凉了,然后就心疼电费,又关掉。
总是短时间地开关空调,实际上更费电,而且容易造成空调压缩机的损坏。

4、“除湿”比“制冷”更省电
遇上湿热的天气,其实只要开个“除湿”模式,既能让室内湿度降下来,还有着“制冷模式”下的凉快效果,而且,“除湿”比“制冷”更省电。
广东朋友们若是遇上回南天,不妨试试这个方法~
和“在看”
编辑:木木


